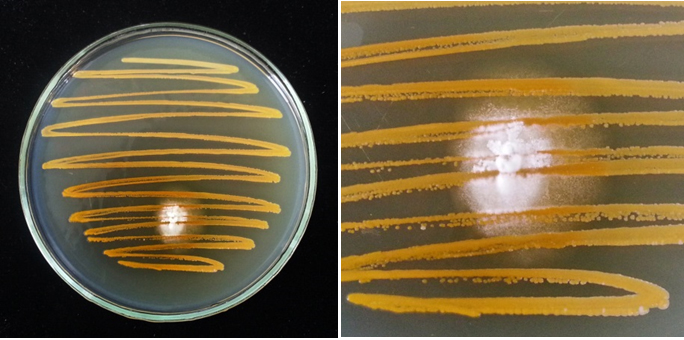

โดย ภูริ ศิวสิริการุณย์
Illness is the night-side of life, a more onerous citizenship. Everyone who is born holds dual citizenship, in the kingdom of the well and in the kingdom of the sick. Although we all prefer to use only the good passport, sooner or later each of us is obliged, at least for a spell, to identify ourselves as citizens of that other place.
Susan Sontag, Illness as Metaphor, 1988, p.3
คงจะกล่าวไม่เกินจริงนัก หากพูดว่าสุขภาพที่ดีและการป่วยไข้เป็นสองด้านของเหรียญเดียวกัน เราต่างเกิดมาในโลกของคนสุขภาพดีและคนป่วยไข้ หากแต่เรานั้นพึงถือบัตรผ่านในโลกของคนสุขภาพดีเพียงอย่างเดียว ทว่าในไม่ช้าก็เร็ว เราจะถูกยื่นบัตรผ่านของอีกโลกในช่วงใดช่วงหนึ่งของชีวิต หน้าที่สำคัญของแพทย์คือการรักษาภาวะที่ผิดปกติของร่างกาย (abnormalities) หรือพยาธิสภาพ (pathology) พยาธิสภาพบางอย่างเกิดแต่เนื้อในร่างกาย พยาธิสภาพบางอย่างเกิดจากสภาวะภายนอกที่อาจระบุสาเหตุได้ยาก พยาธิสภาพนั้นทำให้เกิดโรค (disease) ซึ่งเป็นความผิดปกติที่เราต้องหาสาเหตุเพื่อที่จะกำจัดมัน โรคบางโรคก็ง่ายต่อการรักษาแต่บางก็ไร้ซึ่งหนทางแก้ไข มนุษย์ชาติเราต่อสู้กับโรคที่ไม่รู้จักมาช้านาน หลายโรคหลากพันธุ์ แต่มนุษย์มักก้าวตามพัฒนาการของโรคช้าไปหนึ่งก้าวเสมอคือ ‘โรคติดเชื้อ’ (Infectious Disease) กล่าวคือแม้เราจะวิ่งเร็วแค่ไหนก็เหมือนอยู่กับที่ เพราะโรควิวัฒนาการหนีเราไปทุกห้วงขณะ

รูปที่ 1. เจ้าหน้าที่ทางการแพทย์ที่ศูนย์บำบัดอีโบลา ทำงานเพื่อพาชายคนหนึ่งที่มีอาการเพ้อคลั่งจากอีโบลากลับเข้าไปในแผนกแยกโรคซึ่งเขาหลบหนี ในเมืองเฮสติงส์ ประเทศเซียร์ราลีโอน เมื่อวันอาทิตย์ที่ 23 พฤศจิกายน 2014
หนังสือ Infectious Disease: A Very Short Introduction โดย Marta Wayne นักนิเวศวิทยาเชิงทฤษฎีแห่งมหาวิทยาลัยแมคมาสเตอร์ และ Benjamin Bolker นักพันธุศาสตร์วิวัฒนาการแห่งมหาวิทยาลัยฟลอริดา ได้รจนาบทนำสู่โรคติดเชื้ิอไว้เมื่อปี 2015 แต่ใครจะไปรู้ว่าอีก 5 ปีต่อมา โลกของเราจะจะเผชิญหน้ากับภาวะโลกติดเชื้อจากการระบาดระดับโรคระบาดทั่ว (pandemic) ของเชื้อ SARS-CoV-2 ที่ก่อให้เกิดโรค COVID-19 ในมนุษย์ การระบาดครั้งใหญ่ในปี 2020 ทำให้มนุษย์อย่างเราต้องคำถามว่าเราจะต่อสู้กับโรคคนติดเชื้ออุบัติใหม่ที่พร้อมจะอุบัติซ้ำได้อย่างไร

รูปที่ 2. บุคลากรทางการแพทย์กำลังรักษาผู้ป่วย COVID-19 ที่มีอาการวิกฤตในห้อง ICU ในเซาเปาโล ประเทศบราซิล เมื่อเดือนพฤษภาคม 2020; จาก Wikimedia Commons
ตลอดประวัติศาสตร์ของมนุษยชาติ เราต้องเผชิญกับโรคติดเชื้อมามากมายหลายครั้ง หากพิจารณาเพียงแค่โรคระบาดทั่วเพียงอย่างเดียว มนุษย์นั้นผ่านโลกของโรคติดเชื้อมาหลายครั้ง ไม่ว่าจะจากกาฬโรค ไข้หวัดใหญ่ อหิวาตกโรค มาลาเลีย HIV/AIDS รวมถึงล่าสุดอย่าง COVID-19 แต่ละครั้งเราก็สรรหาความรู้มาต่อสู้กับมันจนผ่านไปได้และหาวิธีป้องกันได้เสมอแม้จะไม่สามารถจัดการได้เบ็ดเสร็จ แต่ก็ไม่สามารถการันตีได้ว่าครั้งต่อไปเราจะจัดการมันได้เช่นครั้งก่อน ๆ
จาก Infectious Disease: A Very Short Introduction สู่ ‘เมื่อโลกติดเชื้อ:ฉบับกระชับ’ แปลโดย ปารุกส์ เกยุราพันธ์ และป๋วย อุ่นใจ ตีพิมพ์สองปีหลังการระบาดครั้งใหญ่ โลกของเราในตอนนั้นอยู่ในภาวะฟื้นตัวจากการติดเชื้อที่ไม่มีใครตั้งรับทัน เหล่านักวิทยาศาสตร์ต้องสรรหาเทคโนโลยีทางชีวภาพมากมายมาเพื่อยุติการติดเชื้อครั้งนี้ให้เร็วที่สุด โดยเทคโนโลยีที่ใหม่แกะกล่องและถูกหยิบนำมาใช้คือวัคซีนแบบ mRNA การนำเทคโนโลยีนี้มาใช้กำราบเชื้อไวรัสนับว่าประสบความสำเร็จในระดับที่โลกกลับมาอยู่ในสภาวะปกติได้ จนสองนักวิทยาศาสตร์อย่าง Katalin Karikó และ Drew Weissman ได้รับรางวัลโนเบลสาขาสรีรวิทยาหรือการแพทย์ในปี 2023 จากการค้นพบการดัดแปลงเบสนิวคลิโอไซด์ที่ช่วยเพิ่มประสิทธิภาพให้กับวัคซีน mRNA เพื่อต่อสู้กับ COVID-19
อย่างน้อยเราก็ไม่อาจคิดได้ว่าโรคติดเชื้อเป็นเรื่องอะไรที่ไกลตัว ดังที่เห็นจากกรณีของ COVID-19 ที่ไม่เพียงแต่กระทบปัจเจกหรือภูมิภาคแต่แพร่กระจายไปทั่วโลก การรับรู้ เข้าใจและให้ความสำคัญต่อความรู้เกี่ยวกับโรคติดเชื้อควรเกิดขึ้นตั้งแต่ระดับปุถุชนคนทั่วไป เราไม่ควรโยนภาระความสนใจนี้ให้แต่แพทย์และนักวิทยาศาสตร์เพียงอย่างเดียว แต่ทั้งประชาชนเองและรัฐต้องสร้างความตระหนักร่วมกัน การจะให้คนทั่วไปหรือรัฐมาอ่านงานวิจัยทางวิทยาศาสตร์โดยตรง ก็อาจจะยากและเป็นความพยายามที่เกินความจำเป็น ทั้งศัพท์แสงและเทคนิคมากมาย ‘เมื่อโลกติดเชื้อ:ฉบับกระชับ’ เล่มนี้จึงเป็นทางเลือกที่ดีสำหรับผู้อยากเข้าใจองค์ความรู้เบื้องต้นเกี่ยวกับโรคติดเชื้อในทางวิทยาศาสตร์การแพทย์ และอาจต่อยอดไปสู่การอ่านงานวิจัยต่อไป
โรคติดเชื้อไม่ใช่เรื่องไกลตัว
เราอาจเห็นโรคติดเชื้อผ่านทางวรรณกรรมซึ่งเป็นเหมือนบันทึกเกี่ยวกับโลกผ่านสายตาของนักเขียนในแต่ละยุคสมัย ย้อนกลับไปตั้งแต่วรรณกรรมเรื่องบันเทิงทศวาร (The Decameron) ของ Giovanni Boccaccio อันเป็นงานรวมเรื่องเล่าของหนุ่มสาวเจ็ดคนที่หนีกาฬโรคจนเกิดอาการเบื่อหน่ายจึงผลัดกันเล่าเรื่องต่างๆ เป็นเวลาสิบวัน วันละเจ็ดเรื่อง หรืออย่างในความตายที่เวนิช (Death in Venice) ของ Thomas Mann ที่พูดถึงการะบาดของอหิวาตกโรคในเวนิช นวนิยายอย่าง The Plague ของ Albert Camus ก็พูดถึงการระบาดของอหิวาตกโรคในอัลจีเรียภายใต้การปกครองของฝรั่งเศส หรือนวนิยายของนักเขียนชาวโคลัมเบียอย่าง Gabriel García Márquez อย่าง ว่าด้วยความรักและบรรดาปีศาจ (Of Love and Other Demons) ก็พูดถึงเด็กสาวที่ตายจากการติดเชื้อพิษสุนัขบ้า อาจเรียกได้ว่าโรคติดเชื้อไม่เพียงปรากฏแต่ในประวัติศาสตร์แบบที่เราเห็นได้ชัดแต่ยังปรากฏในงานวรรณกรรมอีกด้วย โรคติดเชื้อจึงใกล้ตัวมากกว่าที่คิดเพราะกระจายอยู่ทุกอณูของชีวิต

รูปที่ 3. วรรณกรรมที่เกี่ยวข้องกับโรคติดเชื้อ
เมื่อเราเห็นคร่าวๆ แล้วว่าโรคติดเชื้อปรากฏต่อการรับรู้ของมนุษย์อย่างไรในประวัติศาสตร์และวรรณกรรม ต่อไปจะชวนพูดถึงโรคติดเชื้อในฐานะวัตถุแห่งการศึกษาของวิทยาศาสตร์ ใน ‘เมื่อโลกติดเชื้อ:ฉบับกระชับ’ กล่าวถึงความรู้พื้นฐานของโรคติดเชื้อตั้งแต่เชื้อก่อโรค (pathogens) ที่หมายรวมจุลชีพอย่างไวรัส แบคทีเรีย และเชื้อราที่ก่อโรค จนถึงมาตราการการจัดการโรคอย่างการกักตัว (quarantine) และการสร้างภูมิคุ้มกัน (Immunization) ที่เป็นเหมือนการจัดหาอาวุธป้องกันโรคติดเชื้อ การทำความเข้าใจโรคติดเชื้อนอกจากเข้าใจตัวเชื้อเองแล้ว ‘เมื่อโลกติดเชื้อ ฉบับกระชับ’ ยังชี้ถึงปัจจัยเชิงนิเวศวิทยา วิวัฒนาการ และพันธุศาสตร์อันส่งผลอย่างมีนัยสำคัญต่อรูปแบบของการติดเชื้อ พลวัตน์ของเชื้อและวิธีการรับมือเพื่อกำจัดเชื้อ ซึ่ง ‘เมื่อโลกติดเชื้อ:ฉบับกระชับ’ ได้นำเสนอออกมาอย่างเข้าใจง่ายและเห็นภาพตาม
จุดที่น่าสนใจที่อาจทำให้ ‘เมื่อโลกติดเชื้อ ฉบับกระชับ’ น่าหยิบมาอ่านมากขึ้น คือการไม่ได้พูดถึงแต่ความรู้เชิงระบาดวิทยา โมเดลทางคณิตศาสตร์ หรือความรู้ทางภูมิคุ้มกันวิทยา แต่ยกตัวอย่างโรคระบาดที่สำคัญในประวัติศาสตร์โดยเน้นไปที่โรคติดเชื้อที่เรายังคงรบรากับมันไม่เลิก ทั้งนี้ไม่ใช่เพราะโรคอื่น ๆ ไม่น่าสนใจหรือไม่สำคัญ แต่เพราะด้วยชื่อฉบับกระชับจึงต้องเลือกสรรประเด็นที่น่าสนใจและเห็นภาพได้ง่าย การยกตัวอย่างโรคเหล่านี้ช่วยให้เราประยุกต์และเข้าใจโรคติดเชื้ออื่น ๆ ได้อีก นอกจากโรคติดเชื้อในคนแล้ว ‘เมื่อโลกติดเชื้อ: ฉบับกระชับ’ ยังไม่ละเลยที่จะพูดถึงโรคติดเชื้อที่พ้นไปจากมนุษย์อย่าง Batrachochytrium dendrobatidis ที่แพร่ระบาดในสัตว์สะเทินน้ำสะเทินบน
เริ่มต้นด้วย โรคไข้หวัดใหญ่ (Influenza) หรือ flu เป็นโรคติดเชื้อที่เราต้องเผชิญหน้าทุกปี เชื้อไข้หวัดใหญ่มีการพัฒนาตัวเองตลอดเวลาทำให้มนุษย์ต้องผลิตวัคซีนมาแข่งกับวิวัฒนาการของมัน การเปลี่ยนแปลงของเชื้อไข้หวัดใหญ่ทั้งน่าสนใจและน่าตระหนกในเวลาเดียวกัน เพราะมันสามารถเปลี่ยนแปลงตัวเองอย่างรวดเร็วจนร่างกายไม่คุ้นชินและไม่สามารถตรวจจับหรือสร้างภูมิคุ้มกันได้ ดังนั้นจึงเป็นเหตุผลที่ว่าเราต้องฉีดวัคซีนไข้หวัดใหญ่ทุก ๆ ฤดูหนาวของทุกปี

รูปที่ 4. อาการของไข้หวัดใหญ่ และการป้องกันด้วยการฉีดวักซีนปีละครั้ง จาก https://www.sikarin.com/health/ไข้หวัดใหญ่-มีอาการอย่า
นอกจากจะเล่าถึงกลไกการวิวัฒน์และการกลายพันธุ์ของเชื้อแล้ว ในบทนี้ยังพาไปสำรวจเรื่องมาตารฐานทางจริยธรรมในการตีพิมพ์งานวิจัยที่เกี่ยวข้องกับการศึกษาเชื้อไข้หวัดใหญ่ในปี 2011 อีกด้วย ซึ่งการสนใจมิติทางสังคมและการเมืองของวิทยาศาสตร์ก็มีความสำคัญไม่แพ้มิติวิทยาศาสตร์โดด ๆ เพราะนั่นจะเป็นตัวบ่งบอกว่า รัฐหรือสังคมจะมีมาตรการการจัดการต่อโรคระบาดต่อไปอย่างไร การใช้ความรู้เกี่ยวกับไข้หวัดใหญ่จะมีทิศทางแบบใดและเราควรจัดการการระบาดและแจกจ่ายวัคซีนป้องกันอย่างไร
ต่อมาที่ HIV/AIDS ที่ไม่เพียงแต่สร้างแแรงกระเพื่อมในวงการการแพทย์หากแต่ยังสร้างผลกระทบในเชิงสังคมและวัฒนธรรมอีกด้วย HIV/AIDS เริ่มเป็นที่รู้จักในช่วงทศวรรษ 1990 โดยรายงานการติดเชื้อเริ่มในหมู่คนรักร่วมเพศ ทำให้ HIV/AIDS ถูกมองว่าเป็นโรคติดต่อทางเพศสัมพันธ์ที่มีจุดเริ่มต้นจากกลุ่มคนรักร่วมเพศ กระนั้นที่มาของโรคก็น่าฉงนสนเท่ห์ไม่ต่างการวิวัฒนาการของเชื้อ HIV/AIDS เป็นเชื้อก่อโรคที่มนุษย์รับมาจากลิงชิมแปนซีอีกทอดหนึ่งด้วยวิธีการใดก็มิอาจทราบได้ แต่ที่แน่ชัดคือเชื้อนั้นติดผ่านการสัมผัสของเหลวจากร่างกายไม่ว่าจะเลือด เสมหะหรือน้ำอสุจิ HIV/AIDS มีพัฒนาการที่รวดเร็วและเปลี่ยนแปลงทางพันธุกรรมที่ยากจะคาดเดาได้ยิ่งกว่าไข้หวัดใหญ่ ทำให้ผลิตวัคซีนในการรักษา HIV/AIDS นั้นเป็นไปได้ยาก แม้ทางของวัคซีนจะดูเป็นไปได้ยากแต่ในบทนี้ชวนเราไปสำรวจวิธีการรักษาที่น่าสนใจอีกทางซึ่งก็มีข้อจำกัดจากพลวัฒน์ของตัวเชื้อและตัวโฮสต์

รูปที่ 5. แผนภูมิต้นไม้ไฟโลจีเนติกของเชื้อเอชไอวี
จากสองบทแรก เมื่อโลกติดเชื้อ ฉบับกระชับ ชี้ชวนให้พินิจโรคติดเชื้อไวรัสที่มีประเด็นสำคัญที่การกลายพันธุ์ (mutation) ที่เราคาดการณ์ไม่ได้ การกลายพันธุ์อาจเป็นผลดีหรือผลเสียต่อตัวโรคเองก็ตอบได้ยากพอกับที่เราจะคาดเดาเส้นทางการกลายพันธุ์ ถึงจุดนี้อาจทำให้เราเห็นปัจจัยเชิงวิวัฒนาการว่ามีความสำคัญต่อการเข้าโรคติดเชื้อจากไวรัส แต่เหนือสิ่งอื่นใดคือทำให้เรารู้ว่า เราก้าวหลังเชื้อพัฒนาตัวเองไปหนึ่งก้าวเสมอ ทางเดียวที่เราทำได้คือการพยายามสร้างภูมิคุ้มกันหมู่ (Herd immunity) พร้อมกับหาทางรักษาเพื่อจำกัดวงของการติดเชื้อ เป้าหมายที่เป็นไปได้ในทางระบาดวิทยาไม่ใช่ไม่มีติดเชื้อเลยแต่สร้างภูมิคุ้มกันหมู่และรักษาอาการของผู้ติดเชื้อต่อไปได้ให้มีชีวิตรอด แลดูเหมือนว่าความสัมพันธ์ระหว่างมนุษย์และเชื้อไวรัสเป็นสภาวะอาศัยร่วมกันทั้งในเชิงนิเวศวิทยาและวิวัฒนาการ
บทต่อมาพูดถึงเชื้ออหิวาตกโรค ซึ่งแตกต่างจากเชื้อโรคไข้หวัดใหญ่และ HIV/AIDS เพราะเป็นเชื้อแบคทีเรีย จึงมีกลไกการก่อโรคและแพร่เชื้อที่ต่างกัน การรักษาและป้องกันก็ต่างกันไปด้วย การรักษาและป้องกันโรคจากเชื้อไวรัสอาจมีหลายวิธี แต่สำหรับแบคทีเรียเราสามารถจัดการมันผ่านยาปฏิชีวนะได้ซึ่งแลดูง่ายกว่า ทว่าการใช้ยาปฏิชีวนะอาจทำให้เกิดสภาวะเชื้อดื้อยา (drug-resistant infection) ขึ้น กล่าวคือเชื้อแบคทีเรียสามารถต้านทานต่อยาปฏิชีวนะได้ นอกจากการใช้ยาปฏิชีวนะในการรักษาโรคติดเชื้อแบคทีเรีย เราเรียนรู้ว่าสามารถใช้ไวรัสที่เรียกว่าเฟจในการต่อสู้กับแบคทีเรียที่เฉพาะเจาะจงได้ซึ่งดูเหมือนจะเป็นทางออกของการดื้อยาปฏิชีวนะของแบคทีเรียแต่กระนั้นก็ยังมีจุดอ่อนอยู่ในแง่วิวัฒนาการของไวรัสดังที่กล่าวมาข้างต้น
รูปที่ 6. ภาพซ้าย Penicillium sp. และ Staphylococcus aureus ในจานเพาะเชื้อ; ภาพขวา Staphylococcus aureus ที่ดื้อยาสามารถเจริญเติบโตได้บนโคโลนีของ Penicillium sp.; จาก http://biology.ipst.ac.th/?p=979
ในมิติทางประวัติศาสตร์และสังคม อหิวตกโรคนำการเปลี่ยนแปลงมาสู่วงการแพทย์และสภาพสังคม ทั้งจากการระบาดครั้งแรกในเบงกอล มาถึงการศึกษาและวางรากฐานวิชาระบาดวิทยาของ John Snow ที่นอกจากจะบ่งชี้ที่มาของโรคและปัจจัยการระบาดแล้วยังสร้างการเปลี่ยนแปลงสภาพความเป็นอยู่ชาวลอนดอน เกิดการจัดระเบียบย่านแออัดในลอนดอนและการจัดระบบน้ำใหม่อันเสริมสร้างสุขภาวะของประชาชน ในส่วนของประเทศไทย อหิวาตกโรคเป็นโรคระบาดที่มีมาอย่างช้านานด้วยเพราะสังคมไทยใช้ชีวิตติดแหล่งน้ำจึงไม่แปลกที่จะเกิดการระบาดของเชื้ออหิวาตกโรค และเพราะเชื้อตัวนี้เองที่ทำให้สยามเริ่มจัดการระบบสาธารณสุขขึ้น เช่น การจัดการเกี่ยวกับส้วมและอุจจาระ เพื่อป้องกันการแพร่กระจายของโรคผ่านอุจจาระที่อาจปนเปื้อนเชื้อ จนเริ่มเกิดโรงพยาบาลเพื่อรักษาอหิวาตกโรคและโรคอื่นๆ (อ่านเพิ่มเติมที่ ประวัติศาสตร์สังคมว่าด้วยส้วม โดย มนฤทัย ไชยวิเศษ และเชื้อโรค ร่างกาย และรัฐเวชกรรม: ประวัติศาสตร์การแพทย์สมัยใหม่ในสังคมไทย ของ ทวีศักดิ์ เผือกสม)
อีกโรคติดเชื้อที่เราคนไทยคุ้นเคยกันดีคือโรคมาลาเลีย อันมีเหตุมาจากที่โรคมาลาเรียนี้เองที่พรากชีวิตเจ้าชีวิตอย่างพระบาทสมเด็จพระจอมเกล้าเจ้าอยู่หัว รัชกาลที่ 4 หลังการชมสุริยุปราคาที่หว้ากอที่เรียกได้ว่าแสดงถึงเอาความเป็นสมัยใหม่ของสยาม เหตุการณ์ครั้งนั้นทำให้พระบรมวงศานุวงศหลายพระองค์ติดไข้ป่านี้มารวมถึงพระหน่ออย่างเจ้าฟ้าจุฬาลงกรณ์หรือพระบาทสมเด็จพระจุลจอมเกล้าเจ้าอยู่หัวในเวลาต่อมา (อ่านเพิ่มเติมที่พระจอมเกล้าฯ พยากรณ์: ความย้อนแย้งของ “ดาราศาสตร์” กับ “โหราศาสตร์” ในสังคมไทยสมัยใหม่ บรรณาธิการโดย สิกขา สองคำชุม)
มาลาเรียต่างจากทั้งโรคไข้หวัดใหญ่และ HIV/AIDS ที่มาจากไวรัสและอหิวตกโรคที่มาจากแบคทีเรีย มาลาเรียมีโปรโตซัวในกลุ่มพลาสโมเดียมเป็นเชื้อก่อโรคโดยมียุงก้นป่องเป็นพาหะของโรค มาลาเรียเป็นโรคที่มีความพิเศษกว่าโรคติดเชื้อที่กล่าวไปข้างต้นตรงที่ปัจจัยเชิงนิเวศวิทยามีผลอย่างมากต่อการติดเชื้อ มาลาเรียเริ่มเป็นที่รับรู้ของชาวตะวันตกช่วงล่าอาณานิคม และด้วยความพยายามในการรักษาชีวิตเจ้าอาณานิคมจึงมีการศึกษาแนวทางรักษาและป้องโรคดังที่พบในเครื่องดื่มยอดฮิตอย่าง Gin&Tonic ที่มีตัวยาควินินที่ใช้รักษาโรคไข้จับสั่นซึ่งเป็นอาการหนึ่งของโรคมาลาเรียในระยะที่เกิดการแตกตัวของเม็ดเลือดแดง มาลาเรียกลายมาเป็นวัตถุสำหรับการศึกษาของเวชศาสตร์เขตร้อน (Tropical Medicine) ที่เกิดขึ้นในประเทศอาณานิคมไม่ว่าจะในแอฟริกาหรือเอเชียตะวันออกเฉียงใต้ มาลาเรียยังสะท้อนถึงสภาพสังคมและการเข้าถึงการรักษาของประชนทำให้มาลาเรียกลายเป็นโรคที่มักเกิดในคนจนของประเทศกำลังพัฒนามากกว่าประเทศที่พัฒนาแล้ว

รูปที่ 7. วงจรชีวิตของปรสิตมาลาเรีย ยุงก่อให้เกิดการติดเชื้อโดยการดูดเลือด ขั้นแรก สปอโรซอยต์เข้าสู่กระแสเลือด และเดินทางไปยังตับ สปอโรซอยต์เหล่านี้เข้าไปติดเชื้อเซลล์ตับ ที่ซึ่งมีการเพิ่มจำนวนเป็นเมอโรซอยต์ ทำให้เซลล์ตับแตก และกลับเข้าสู่กระแสเลือด จากนั้น เมอโรซอยต์ติดเชื้อเซลล์เม็ดเลือดแดง ที่ซึ่งเจริญเป็นระยะวงแหวน (ring form) ซึ่งโทรโพซอยต์และชิซอนต์จะผลิตเมอโรซอยต์มากขึ้นอีก นอกจากนี้มีการผลิตแกมีโทไซต์เช่นกัน ซึ่งหากยุงได้รับระยะนี้เข้าไป จะไปติดเชื้อในตัวยุงและมีการเจริญเป็นตัวเต็มวัยต่อไป; จาก Wikimedia Commons
การต่อสู้กับมาลาเรียต่างจากการต่อสู้กับไข้หวัดใหญ่และ HIV/AIDS รวมถึงอหิวาตกโรค ด้วยเพราะเชื้อก่อโรคเป็นโปรโตซัวที่มีความซับซ้อนในระดับพันธุกรรมสูง แม้จะไม่ได้กลายพันธุ์อย่างง่ายดายอย่างเช่นไวรัสแต่ก็มีข้อจำกัดในการจัดการอยู่ดี ด้วยความรู้ที่ว่ายุงเป็นพาหะของมาลาเรียทำให้การกำจัดเชื้อมาคู่การกำจัดพาหะนั่นก็คือยุง การจัดการกับมาลาเรียจึงดูมีความเป็นไปได้สูงและการต่อสู้ในเชิงวิวัฒนาการก็ไม่รุนแรงเท่าไวรัสและแบคทีเรีย กระนั้นการจัดการมาลาเรียก็มีข้อจัดด้านโลจิสติกของการรักษา สังคมและวัฒนธรรมอยู่ดี
โรคสุดท้ายที่ ‘เมื่อโลกติดเชื้อ:ฉบับกระชับ’ นำมาพูดคุยคือ Batrachochytrium dendrobatidis ซึ่งเป็นเชื้อราก่อโรคในสัตว์สะเทินน้ำสะเทินบก การศึกษาโรคติดเชื้อในสิ่งมีชีวิตอื่นที่ไม่ใช่มนุษย์ใช่ว่าไม่สำคัญ ดังกรณีของเฟจที่ใช้กำจัดแบคทีเรีย การเข้าใจกลไกของเชื้อในสิ่งมีชีวิตอื่นช่วยให้เราสร้างองค์ความรู้ในการประยุกต์กับมนุษย์ แต่ก็เพราะเป็นโรคที่เกิดในสปีชี่ส์อื่นทำให้เราขาดทั้งความรู้และทรัพยากรในการศึกษาและจัดการกับโรค การหยิบเอา Batrachochytrium dendrobatidis ในบทสุดท้ายนอกจากจะชี้ถึงปัญหาที่เกี่ยวกับมนุษย์โดยตรงอย่างการสูญพันธุ์ของกบที่อาจสร้างมูลค่าทางเศรษฐกิจแล้ว ในบทนี้ยังชี้ชวนให้เราคิดถึงประเด็นหลังมนุษย์นิยมและแอนโทรโปซีน (Anthropocene) เมื่อมนุษย์มีส่วนสำคัญในการเปลี่ยนแปลงธรรมชาติ

รูปที่ 8. คางคกสีทองแห่งมอนเตเบร์เด ประเทศคอสตาริกา เป็นหนึ่งในสัตว์ครึ่งบกครึ่งน้ำที่มีการเสียชีวิตเป็นจำนวนมาก
เมื่อชี้ถึงสาเหตุของโรคมาแล้ว ‘เมื่อโลกติดเชื้อ:ฉบับกระชับ’ ก็ปิดจบด้วยหนทางต่อไปในอนาคต นับว่าเป็นบทสุดท้ายแต่ไม่ท้ายสุด เพราะชวนให้เราคิดถึงการต่อสู้กับโรคติดเชื้อต่อไป ‘เมื่อโลกติดเชื้อ:ฉบับกระชับ’ จึงเป็นมากกว่าบทนำที่พาเราไปสำรวจโลกของโรคติดเชื้อแต่ชวนให้เราคิดถึงทางออกของปัญหานี้ เราจะมีวิธีป้องกันโรคติดเชื้อที่มีอยู่หรือโรคอุบัติใหม่อย่างไร หรือเราต้องอยู่ร่วมกันกับโรคในโลกที่ติดเชื้อ ขอชวนไปสำรวจเพื่อสร้างคำถามที่ก่อความคิดใน ‘เมื่อโลกติดเชื้อ:ฉบับกระชับ’
Illuminations Editions
| หน้าที่เข้าชม | 204,927 ครั้ง |
| ผู้ชมทั้งหมด | 138,198 ครั้ง |
| เปิดร้าน | 8 เม.ย. 2563 |
| ร้านค้าอัพเดท | 9 ธ.ค. 2568 |